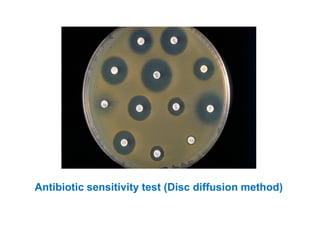
Antibiotic sensitivity test (Disc diffusion method)

This document outlines various methods used to identify unknown bacterial species, including microscopic examination, culture-based techniques, biochemical tests, serological identification, and molecular methods. Microscopic examination involves staining bacterial smears to determine cell morphology and arrangement. Cultural characteristics like colony morphology, pigmentation, and hemolysis are also examined. Biochemical tests identify metabolic pathways and enzyme production. Serological tests use antibodies to identify species. Molecular methods like PCR and DNA probes allow for rapid and accurate identification compared to older phenotypic techniques. A combination of these methods is usually required to definitively identify an unknown bacterial species.